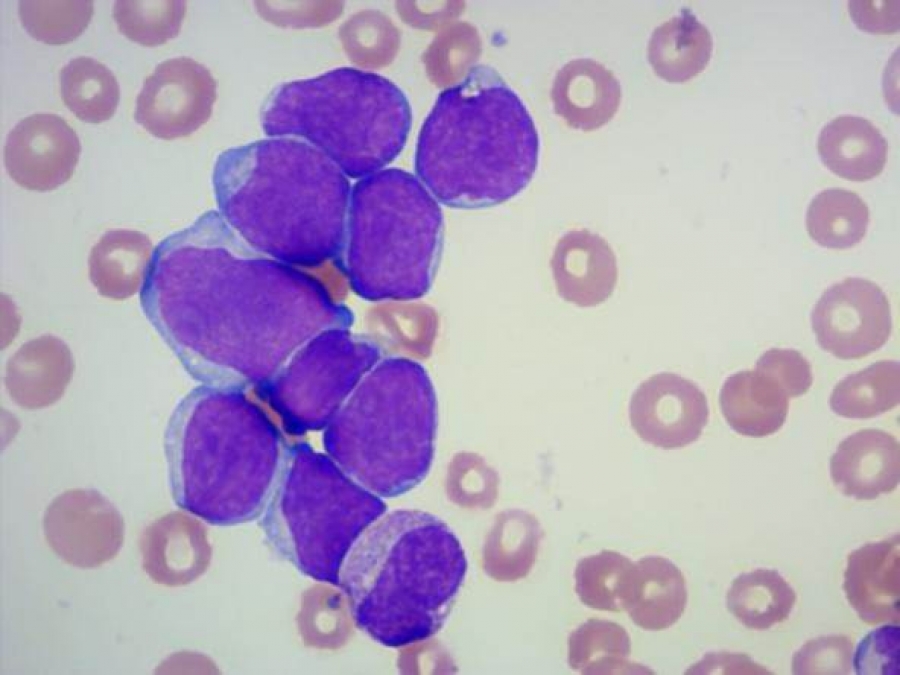
La Leucemia Acuta Mieloblastica di Tipo 4

La leucemia megacarioblastica acuta è una rara forma di Leucemia mieloide acuta, di cui ne costituisce il 5% delle diagnosi. Colpisce i megacariociti, i percusori dei trombociti.
È la più comune forma di leucemia nei bambini affetti da Sindrome di Down.
Epidemiologia
È una malattia rara nella popolazione sana, è più frequente nelle persone con sindrome di Down.
Trattamento
La terapia si basa sulla chemioterapia e il trapianto ematopoietico, si stanno mettendo a punto terapie per aumentare la sopravvivenza in questa patologia.
Prognosi
La prognosi è variabile, la sopravvivenza della leucemia megacarioblastica con la Sindrome di Down supera il 90%, mentre nel resto degli individui è piuttosto scarsa ed è di circa il 40-50%.
Voci correlate
- Leucemia mieloide acuta
- Leucemia
- Sindrome di Down
- Leucemia eritroide acuta